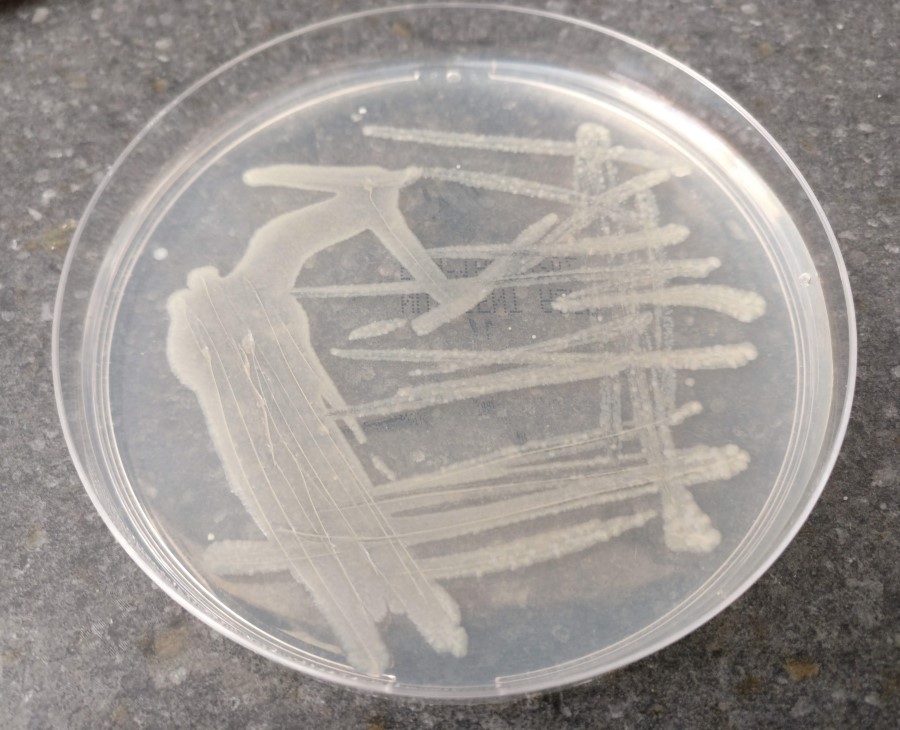

|
|||||||||||||
|
|
||||||||||||||||||||
|
|||||||||||||||||||||

Questions or comments? Send mail to Ken AT bigpumpkins.com.
Copyright © 1999-2026 BigPumpkins.com. All rights reserved.

|
|
||||||||||||||||||||||||||
| Grower Diaries | |||||||||||||||||||||||||||
|
|||||||||||||||||||||||||||
|
|||||||||||||||||||||||||||
|
Top of Page Questions or comments? Send mail to Ken AT bigpumpkins.com. Copyright © 1999-2026 BigPumpkins.com. All rights reserved. |
|||||||||||||||||||||||||||